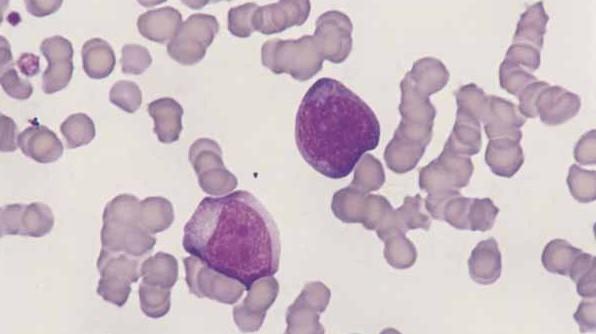
lymphocytes

لنفوسیت ها (lymphocytes) یکی از انواع گلبولهای سفید هستند که نقش حیاتی در حفظ و ارتقای سلامت سیستم ایمنی بدن دارند.
این سلولها با تشخیص و مقابله با عوامل خارجی و بیماریزا، مانند باکتریها، ویروسها و قارچها، از بدن در برابر عفونتها و بیماریها محافظت میکنند. لنفوسیتها به دو نوع اصلی تقسیم میشوند: لنفوسیتهای B و T. لنفوسیتهای B مسئول تولید پادتنها (آنتیبادیها) هستند که به بدن در شناسایی و خنثیسازی عوامل بیماریزا کمک میکنند، در حالی که لنفوسیتهای T به طور مستقیم سلولهای آلوده و سلولهای سرطانی را شناسایی و نابود میکنند.
این دو نوع لنفوسیت با همکاری یکدیگر یک سیستم دفاعی پیچیده را تشکیل میدهند که به بدن اجازه میدهد تا به صورت مؤثر با تهدیدات مختلف مقابله کند. به همین دلیل، تعداد مناسب لنفوسیتها در خون نشاندهنده سلامت سیستم ایمنی است.
آموزش کامل ترجمه جواب آزمایش حتی برای مبتدی ها بصورت کامل
مقدار نرمال لنفوسیت ها lymphocytes در آزمایش خون
مقدار نرمال لنفوسیتها در آزمایش خون بسته به نوع آزمایش و سن افراد میتواند کمی متفاوت باشد. به طور کلی، درصد نرمال لنفوسیتها در خون برای بزرگسالان بین 20 تا 40 درصد از کل گلبولهای سفید خون است. این مقدار تقریباً برابر با 1,000 تا 4,800 لنفوسیت در هر میکرولیتر خون میباشد.
برای کودکان، میزان نرمال لنفوسیتها ممکن است بالاتر باشد و در برخی از سنین به حدود 30 تا 70 درصد از گلبولهای سفید خون برسد، که معمولاً نشاندهنده فعالیت بالای سیستم ایمنی در سنین پایین است.
اگر میزان لنفوسیتها از محدوده نرمال بیشتر باشد، به آن لنفوسیتوز و اگر کمتر از مقدار نرمال باشد، به آن لنفوپنی گفته میشود.
تعریف بالا بودن لنفوسیت ها (لنفوسیتوز)
بالا بودن لنفوسیتها، یا لنفوسیتوز، وضعیتی است که در آن تعداد لنفوسیتها در خون به میزان غیرطبیعی افزایش مییابد. لنفوسیتوز معمولاً به دلیل واکنش سیستم ایمنی به عفونتها، بیماریهای خودایمنی یا برخی از انواع سرطانها رخ میدهد. در این حالت، بدن به منظور مقابله با عوامل مهاجم یا تهدیدات داخلی، تعداد لنفوسیتها را افزایش میدهد.
برای مثال، در پاسخ به عفونتهای ویروسی مانند آنفولانزا، هپاتیت و ویروس HIV، تعداد لنفوسیتهای خون ممکن است به طور چشمگیری افزایش یابد. همچنین، برخی از بیماریهای خودایمنی مانند لوپوس یا بیماریهای مزمن دیگر نیز میتوانند باعث افزایش لنفوسیتها شوند. در هر صورت، لنفوسیتوز یک نشانه مهم در تشخیص وضعیت سیستم ایمنی بدن است و نیاز به بررسی دقیق پزشکی دارد.
نقش سیستم ایمنی در بالا بودن لنفوسیتها
سیستم ایمنی بدن با ترکیبی از سلولها و مولکولها، همچون لنفوسیتها، از بدن در برابر عوامل خارجی محافظت میکند. لنفوسیتها، به ویژه لنفوسیتهای T، نقش حیاتی در شناسایی سلولهای آلوده و سلولهای سرطانی ایفا میکنند.
لنفوسیتهای T، خود به چند نوع مختلف تقسیم میشوند که هر کدام وظیفه خاصی دارند؛ برخی از آنها وظیفه تخریب سلولهای آلوده را دارند و برخی دیگر در فرآیندهای نظارتی و تقویت سیستم ایمنی شرکت میکنند. از سوی دیگر، لنفوسیتهای B به تولید پادتنها مشغولاند که به بدن در شناسایی و خنثیسازی عوامل بیماریزا کمک میکنند.
با افزایش تعداد لنفوسیتها، بدن تلاش میکند تا با تهدیدات مختلف مبارزه کند، اما در برخی مواقع افزایش غیرطبیعی آنها ممکن است نشاندهنده وجود بیماریهای جدیتری مانند سرطانهای خونی باشد.
علائم بالینی بالا بودن لنفوسیتها
بالا بودن لنفوسیتها lymphocytes یا lymph ممکن است با علائم متعددی همراه باشد که نشاندهنده یک مشکل در سیستم ایمنی بدن هستند. برخی از این علائم شامل خستگی مزمن، تبهای مکرر، تورم غدد لنفاوی و عفونتهای مکرر هستند.
در برخی از موارد شدید، افراد ممکن است کاهش وزن ناگهانی، عرقهای شبانه، و درد در ناحیه شکم یا قفسه سینه را تجربه کنند. این علائم اغلب نشاندهنده این است که بدن در حال مبارزه با یک بیماری یا عفونت جدی است.
هر چند که افزایش لنفوسیتها در خون به خودی خود یک علامت بیماری نیست، اما وجود این علائم در کنار لنفوسیتوز ممکن است پزشکان را به سمت بررسی دقیقتر هدایت کند تا علت اصلی مشکل را شناسایی کنند. تشخیص دقیق این حالت و اقدام به موقع برای درمان آن اهمیت بسیار زیادی دارد، چرا که ممکن است نشاندهنده وجود بیماریهای خطرناکی باشد.
دلایل پزشکی برای بالا بودن لنفوسیتها lymph
علل اصلی بالا بودن لنفوسیتها میتواند بسیار متنوع باشد و به شرایط مختلفی بستگی دارد. یکی از شایعترین دلایل افزایش لنفوسیتها، عفونتهای ویروسی است. در این شرایط، بدن با تولید بیشتر لنفوسیتها تلاش میکند تا با ویروسها مقابله کند.
برای مثال، در هنگام ابتلا به بیماریهایی مانند آنفولانزا، هپاتیت، ویروس HIV و سایر عفونتهای ویروسی، تعداد لنفوسیتها ممکن است به طور قابل توجهی افزایش یابد.
در برخی موارد، بیماریهای خودایمنی مانند لوپوس نیز ممکن است باعث افزایش لنفوسیتها شوند. در این بیماریها، سیستم ایمنی بدن به اشتباه به سلولهای سالم خود حمله میکند، که این امر منجر به افزایش تولید لنفوسیتها میشود.
همچنین، در موارد نادر، افزایش لنفوسیتها ممکن است ناشی از سرطانهای خونی مانند لوسمی باشد. برردقیق دلیل لنفوسیتوز نیاز به بررسیهای پزشکی کامل دارد.
تشخیص بالا بودن لنفوسیتها
تشخیص لنفوسیتوز از طریق آزمایش خون انجام میشود. آزمایش خون یکی از سادهترین و موثرترین راههای ارزیابی تعداد لنفوسیتها در بدن است. پزشک با بررسی تعداد گلبولهای سفید و به ویژه لنفوسیتها، میتواند به وجود یا عدم وجود لنفوسیتوز پی ببرد.
اگر تعداد لنفوسیتها به طور غیرطبیعی بالا باشد، پزشک ممکن است آزمایشهای بیشتری برای تعیین علت اصلی این افزایش انجام دهد. این آزمایشها میتواند شامل آزمایشهای ویروسی، تصویربرداری و حتی بیوپسی مغز استخوان باشد تا دلایل اصلی لنفوسیتوز مانند عفونتها، بیماریهای خودایمنی یا سرطانهای خونی مشخص شوند.
تشخیص دقیق علت بالا بودن لنفوسیتها اهمیت زیادی دارد، زیرا درمان صحیح و به موقع میتواند از بروز عوارض جدیتر جلوگیری کند.
بالا بودن لنفوسیتها و بیماریهای خاص
ارتباط بین بالا بودن لنفوسیتها lymphocytes و برخی بیماریهای خاص مانند سرطانهای خونی بسیار اهمیت دارد.
یکی از این بیماریها لوسمی لنفوسیتی است که در آن تعداد لنفوسیتهای بدن به شدت افزایش مییابد. در این حالت، لنفوسیتها به طور غیرطبیعی تکثیر میشوند و میتوانند به سلولهای خونی سالم حمله کنند. این امر منجر به ضعف سیستم ایمنی بدن و ایجاد عوارض جدی مانند عفونتهای مکرر و ضعف عمومی میشود. لنفوسیتوز میتواند به عنوان یک علامت هشدار برای بیماریهایی مانند لوسمی یا سایر سرطانهای خونی عمل کند.
به همین دلیل، تشخیص سریع و درمان به موقع این بیماریها از اهمیت زیادی برخوردار است. پزشکان معمولاً با انجام آزمایشهای تخصصی، مانند بررسی مغز استخوان و بیوپسی، تلاش میکنند تا این نوع بیماریها را شناسایی و درمان کنند.
پایین بودن lymphocyte در آزمایش خون نشانه چیست؟
پایین بودن لنفوسیت (Lymphocyte) در آزمایش خون که به آن لنفوپنی (Lymphocytopenia) گفته میشود، میتواند نشانهای از مشکلات مختلف در بدن باشد. برخی از علل رایج عبارتاند از:
دلایل پایین بودن لنفوسیت در آزمایش خون
- عفونتهای ویروسی شدید (مانند آنفلوآنزا، کرونا، هپاتیت و HIV)
- اختلالات ایمنی (مانند لوپوس، آرتریت روماتوئید و سایر بیماریهای خودایمنی)
- نارسایی مغز استخوان (مانند سرطانهای خونی، کمخونی آپلاستیک)
- مصرف داروهای سرکوبکننده ایمنی (کورتیکواستروئیدها، شیمیدرمانی)
- کمبود مواد مغذی (مانند کمبود روی، ویتامین B12 و فولات)
- بیماریهای ارثی نقص ایمنی (مانند سندرم دیجورج)
- بیماریهای مزمن (نارسایی کلیوی، کبدی، دیابت)
- استرس شدید و طولانیمدت
- قرار گرفتن در معرض اشعه یا مواد شیمیایی سمی
- سپسیس یا عفونتهای شدید سیستمیک
پایین بودن نوتروفیل و بالا بودن لنفوسیت در کودکان و علت آن
پایین بودن نوتروفیل و بالا بودن لنفوسیت در کودکان معمولاً به دنبال عفونت های ویروسی مانند سرماخوردگی، آنفولانزا یا آبله مرغان دیده میشود. در این شرایط بدن برای مقابله با ویروس ها تعداد لنفوسیت ها را افزایش میدهد.
کاهش نوتروفیل ها میتواند موقتی بوده و پس از بهبودی کودک به حالت طبیعی بازگردد. برخی داروها یا بیماریهای خونی نادر نیز ممکن است این تغییرات را ایجاد کنند.
در صورتی که این وضعیت طولانیمدت باقی بماند نیاز به بررسی تخصصی توسط پزشک وجود دارد. آزمایشهای تکمیلی کمک میکنند علت دقیق مشخص شود.
اگر سطح لنفوسیتهای شما پایین است، بهتر است با پزشک متخصص مشورت کنید تا علت دقیق مشخص شود.
انتخاب آزمایشگاه تشخیص طبی مجهز با پرسنل مجرب در تاثیر نتیجه و دقت آزمایش نقش بسزایی دارد.



بدون دیدگاه